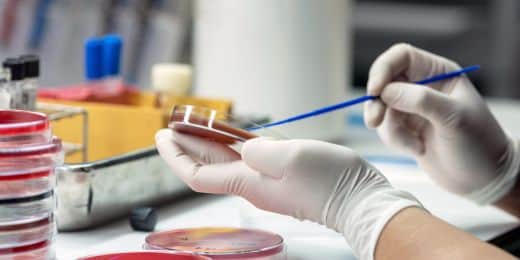
Scientist or laboratory worker swabbing a blood sample to inspect it for contamination

Achieving Zero Blood Culture Contamination
Explore best practices, common sources of error, and quality improvement approaches that help hospitals and blood banks lower blood culture contamination rates and enhance patient safety.

Explore best practices, common sources of error, and quality improvement approaches that help hospitals and blood banks lower blood culture contamination rates and enhance patient safety.
Published 5 May 2026
Article by
6 min read
Blood culture contamination refers to the inadvertent introduction of bacteria and other foreign objects into a blood sample during phlebotomy, sample handling, or transport and storage. This can result in false-positive cultures that compromise diagnosis, affect blood bank stocks, and modify subsequent treatment options, exposing patients to unnecessary medication and additional hospital care.
Blood culture contamination strikes fast in busy clinical settings. The most minor lapse in techniques or sterile prep can introduce bacteria into the sample. In fact, nearly half of all positive blood cultures were identified as such due to contamination. Understand how this happens in blood banks and other clinical settings based on the most common causes below:
Patient skin flora: Considered the top source of contamination, inadequate disinfection allows coagulase-negative staphylococci, Corynebacterium, and Propionibacterium to enter the sample.
Faulty or defective collection equipment: Non-sterile supplies, expired antiseptics, or defective bottles raise risks.
Operator mistakes: Rushing the task and poor venipuncture technique (e.g., repalpating the site after disinfection, touching the needle hub, and failing to change gloves, etc.) can introduce contaminants.
Improper bottle handling: Incorrectly filling bottles (e.g., under or overfilling, failing to maintain the correct order of draw) can introduce harmful microorganisms into the sample.
Environmental factors: When the storage area, work area, or laboratory in general is cluttered and poorly sanitized, airborne particles can compromise the sample's sterility.
Contaminated blood culture samples create serious problems for both patients and healthcare providers. Here are some of the most pressing issues that could arise, according to a US Center for Disease Control and Prevention (CDC) blood culture contamination study:
False positives: Contaminants can mimic actual infections, leading doctors to believe that a patient is septic. This results in unnecessary additional tests, treatments, and delays in accurate diagnosis.
Added resource utilization: Mistakes require repeated blood draws, laboratory tests, documentations, and workflow review. This consumes staff time, increases workload, and raises operational costs.
Antimicrobial misuse: Unnecessary antibiotic use undermines stewardship efforts. It contributes to antimicrobial resistance, exposing patients to side effects.
Prolonged hospitalization: Staying in the facility longer for investigations and monitoring disrupts bed availability, increases financial burdens, and heightens patients’ stress. It can also lead to mismatches in blood supply and inventories.
Utilize advanced sensor technology to monitor assets, automate vital alerts, implement actions, and report urgent issues.
Countries worldwide enforce strict laboratory and patient-safety rules to support blood culture contamination prevention. There are some of the most significant:
Laboratory accreditation: Standards like the ISO 15189 requires laboratories to document their quality management systems, validate procedures for specimen collection, and monitor pre-analytical errors.
Professional standards and technical guidance: The Clinical and Laboratory Standards Institute’s CLSI M47 and the American Society for Microbiology’s ASM guidance detail technical best practices (e.g., antisepsis protocols, bottle handling, interpretation rules) to reduce false positives and know when a culture is contaminated or true bacteremia.
National patient safety initiatives: Programs like the UK’s CQUIN initiative mandates pathway standardization, training, and data-driven improvement projects to reduce contamination and improve sepsis care.
Device and product standards: Bottles, antiseptics, and devices used in the workflows must be approved, continuously monitored, and validated to maintain sterility and performance.
Target blood culture contamination rate: Facilities should set local targets (substantially below 3%, drive to under 1%), monitor trends, and aim for continuous reduction of the BCC rate.
Reporting requirements and surveillance: Laboratories are required to record contamination events, track contamination rates, and report internally to infection prevention and hospital leadership.
Competency and training: Evidence of competency checks and corrective actions when blood culture contamination rates rise are also required to improve the laboratory’s quality control system.
Build from scratch or choose from our collection of free, ready-to-download, and customizable templates.
It is possible to significantly reduce blood culture contamination rates. Many blood banks, laboratories, and clinical facilities have already achieved this by consistently applying proven strategies supported by digital tools that strengthen accuracy, compliance, and accountability in blood culture collection.

5 Ways on How to Prevent Blood Culture Contamination
Organizing every step into an easily replicated system, from chlorhexidine-based skin antisepsis to using diversion devices and closed collection systems, reduces the entry of skin flora into samples. Digital checklists create consistent, error free workflows that substantially lowers contamination. It also creates a time-stamped audit trail that provides evidence of due diligence and supports regulatory compliance.
Automated blood culture devices provide standardized processing data that feed analytics dashboards. When combined with Continuous Quality Improvement (CQI) programs, this can do the following:
Detect contamination spikes in collected samples
Flag positive bottles that indicate microbial growth
Speed up result
Minimize repeat errors
Prevent workflow delays
Problems such as missing diversion devices or breaches in sterile technique should be documented and reported in real time, allowing teams to correct them quickly and protect patients from serious harm.
As always, maintaining an audit trail promotes transparency and accountability, and it supports investigation of recurring incidents so they can be prevented in the future.
Trained phlebotomy teams, laboratory technicians, and medical technologists consistently achieve lower contamination rates than mixed-competency staff. Ongoing digital training modules and documented competency checks reinforce proper technique and updates to standards.
Build a highly skilled workforce that performs collections correctly and reliably with the following healthcare training programs:
Safe patient handling (venipuncture)
Hand hygiene
Skin antisepsis
Specimen diversion
Blood-borne pathogens
Based on the flagged incidents, teams across the facility (e.g., phlebotomist who draws the blood, lab technician who conducts the test, medical technologist who reads the results) can analyze contamination clusters and use those to guide appropriate responses.
These five strategies definitively answer the question: what is the most important factor in preventing contamination of a blood culture? It’s a combination of well-thought-out, standardized workflows and a sustained commitment to staff training and accountability.
On top of all those, utilizing a mobile-accessible platform enhances these essential human-centered workflows by providing real-time feedback and point-of-care guidance. These result in faster action, fewer errors, and consistently lower blood culture contamination rates across the institution.
SafetyCulture is a mobile-first operations platform adopted across industries such as manufacturing, mining, construction, retail, and hospitality. It’s designed to equip leaders and working teams with the knowledge and tools to do their best work—to the safest and highest standard.
Efficiently manage and streamline health and safety processes across the organization, including incident management, safety audits and inspections, risk assessment, waste management, and more, using a comprehensive EHS software solution.
✓ Save time and reduce costs
✓ Stay on top of risks and incidents
✓ Boost productivity and efficiency
✓ Enhance communication and collaboration
✓ Discover improvement opportunities
✓ Make data-driven business decisions
In this article